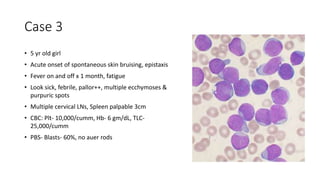
Case 3
• 5 yr old girl
• Acute onset of spontaneous skin bruising, epistaxis
• Fever on and off x 1 month, fatigue
• Look sick, febrile, pallor++, multiple ecchymoses &
purpuric spots
• Multiple cervical LNs, Spleen palpable 3cm
• CBC: Plt- 10,000/cumm, Hb- 6 gm/dL, TLC-
25,000/cumm
• PBS- Blasts- 60%, no auer rods

The document provides information on evaluating and diagnosing thrombocytopenia, including:
1) Normal platelet counts range from 150,000-450,000/microL and are slightly higher in females and younger people. Thrombocytopenia is defined as a platelet count below 150,000/microL.
2) The basic mechanisms of thrombocytopenia include decreased platelet production, ineffective production, increased destruction, increased consumption, and sequestration.
3) Diagnosing thrombocytopenia involves ruling out pseudothrombocytopenia, examining the blood counts, bone marrow, and performing additional lab tests to determine the underlying cause and guide treatment.